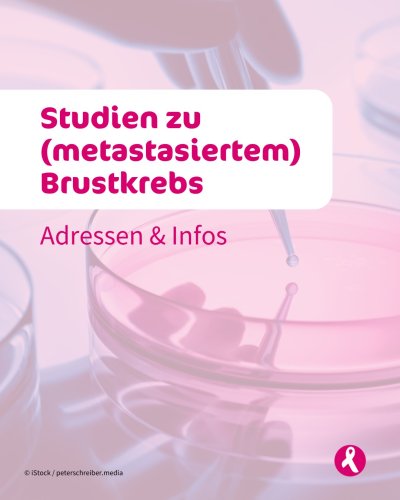
PostPhoto

mamma_mia_brustkrebsmagazin
on August 04, 2025
Schlaflos durch die Nacht? 💤
Wusstet Ihr, dass Schlafprobleme zu den häufigsten Begleiterscheinungen einer Krebserkrankung gehören?
Schlafstörungen bei Krebsp...

mamma_mia_brustkrebsmagazin
on August 01, 2025
News: Stillen erhöht das Rückfallrisiko nicht 💡🙌
Viele junge Frauen wünschen sich nach einer Brustkrebserkrankung nicht nur ein Kind, sondern auch, es stillen ...

mamma_mia_brustkrebsmagazin
on July 30, 2025
Save the Date!!📣
Am 26. & 27. September 2025 ist es so weit:
Der Verein Gynäkologische Krebserkrankungen Deutschland e.V. und die Deutsche Stiftung Eierstockk...

mamma_mia_brustkrebsmagazin
on July 28, 2025
Klinische Studien zu (metastasiertem) Brustkrebs 🔎🏥
In onkologischen Studien werden unter strengen ethischen & gesetzlichen Vorgaben neue Medikamente, Therapie...
mamma_mia_brustkrebsmagazin
on July 25, 2025
Berufsunfähigkeit bei Krebs
Welchen Einfluss hat die Diagnose Krebs auf den Beruf? Was bedeutet berufsunfähig? Und wie kann die Rückkehr in den Beruf gelingen?...

mamma_mia_brustkrebsmagazin
on July 23, 2025
Neuer Webcast zum Thema Fatigue bei Krebs 🎉🥳
Viele Krebspatientinnen und -patienten leiden nicht nur während der Behandlung, sondern auch lange danach unter ei...

mamma_mia_brustkrebsmagazin
on July 22, 2025
Krebs in der Familie – wer hilft den Angehörigen? 👪
Wenn ein geliebter Mensch an Krebs erkrankt, verändert sich das Leben oft für alle – nicht nur für die Betr...

mamma_mia_brustkrebsmagazin
on July 21, 2025
ASCO 2025 - Neues vom weltweit größten Kongress zum Thema Krebs🙌🔎
Wir haben den Kongress aufmerksam verfolgt und euch gemeinsam mit @patientstoday die neusten...

mamma_mia_brustkrebsmagazin
on July 18, 2025
Hallo Ihr Lieben,
heute möchten wir Euch Johanna vorstellen.🙌
Johanna erhält im November 2023 die Diagnose Brustkrebs: zwei Mammakarzinome in der rechten Brus...

mamma_mia_brustkrebsmagazin
on July 16, 2025
Was ist das Cowden-Syndrom?🧬🔎
Das Cowden-Syndrom ist eine seltene, vererbbare Erkrankung, die durch eine Mutation im PTEN-Gen verursacht wird, einem sogenannte...

mamma_mia_brustkrebsmagazin
on July 14, 2025
Zeit, sich auf die Schulter zu klopfen! 💪
In unserer Magazin-Kolumne “Denk an Dich” geht es nur um Euch beziehungsweise Dich! Für Dein persönliches Wachsen, fü...

mamma_mia_brustkrebsmagazin
on July 11, 2025
Sicher Dir jetzt ein Abonnement des Mamma Mia! Das Brustkrebsmagazins, des Mamma Mia! Eierstockkrebsmagazins oder sogar ein Kombi-Abo. 🙌🛍️
Wir möchten Dir und ...

mamma_mia_brustkrebsmagazin
on July 10, 2025
Gesundheitspolitik und Krebs - was Vision Zero für Patienten erreichen möchte
Kein Mensch soll mehr unnötigerweise an Krebs erkranken oder sterben: Im neuen M...

mamma_mia_brustkrebsmagazin
on July 09, 2025
Gesundheitsinformationen im Internet sind schnell zugänglich und immer
verfügbar. Aber kann man den vielen Ratschlägen und Tipps wirklich vertrauen? Und wie unt...

mamma_mia_brustkrebsmagazin
on July 07, 2025
Verpasst? Kein Problem!
Der digitale Mamma Mia! Patientenkongress 2025 im Februar war vollgepackt mit Wissen, das bleibt. 🙌
Über 70 Expertinnen und Experten h...
